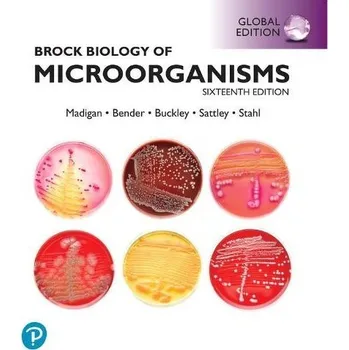
Cizojazyčná kniha Brock Biology of Microorganisms Biology, Global Edition + Mastering Biology with Pearson eText (Package) - Madigan, Michael a Aiyer, Jennifer a Buckley, Daniel a Sattley, W. a Stahl, David

Cutting Edge Third Edition Starter Student's Book + DVD-ROM + Access to MyEnglishLab
- Rok vydání 2014
Engaging texts, new video content and a comprehensive digital package are just some of the features that make this fully…
v 3 obchodech

Engaging texts, new video content and a comprehensive digital package are just some of the features that make this fully…
v 3 obchodech

A Welcome unit of six lessons which introduces pupils to the characters and Family Island, as well as key introductory…
v 3 obchodech

While John Wood was working for Microsoft, he went on vacation to Nepal. There, in a small mountain village, he visited a…
v 10 obchodech

Produkt Power Maths 2nd Edition Practice Book 3B zakoupíte na Bookshop.cz od nakladatele Pearson Education Limited.…
v 5 obchodech

Produkt Talk French Complete (Book/CD Pack) zakoupíte na Bookshop.cz od nakladatele Pearson Education Limited.…
v 3 obchodech

Kniha 9781292749839 Edexcel GCE Politics AS and A-level Student Book 2nd Edition Andrew Colclough,Graham Goodlad,Samantha…
v 2 obchodech

A Welcome unit of six lessons which introduces pupils to the characters and Family Island, as well as key introductory…
v 3 obchodech

A Welcome unit of six lessons which introduces pupils to the characters and Family Island, as well as key introductory…
v 3 obchodech

Learn English through hands-on creative tasks, investigation, projects and experiments with English Code. Children develop a…
v 8 obchodech

Prepare students for the IELTS exam as well as future academic study. With its focus on academic skills, this updated…
v 8 obchodech

Business Partner B1+ Coursebook with eBook and Online Practice - Iwona Dubicka - Business Partner gives students the…
v 11 obchodech

Produkt Business Partner B1 Coursebook & eBook with MyEnglishLab & Digital Resources zakoupíte na Bookshop.cz od nakladatele…
v 6 obchodech

Gold Experience 2nd Edition is a new edition of the fast-paced course that motivates students to build the language and…
v 8 obchodech

Uncas is the last of the Mohican Indians. He is with his father and Hawkeye when they meet Heyward. Heyward is taking the…
v 7 obchodech

This book is the life story and family history of Adeline Yen Mah. Adeline was born in China at a time of great change and…
v 3 obchodech

Sarajevo is under siege. There is little food or water and the city is attacked, every day, from the hills. Ordinary people…
v 9 obchodech

‘It was the seventh day of the storm. We didn’t know where we were. Everyone on the ship believed that death was very near.’…
v 10 obchodech

Marilla and Matthew Cuthbert want a boy from the orphanage to help them on their farm. But a thin little girl is waiting for…
v 12 obchodech

Murder of a stranger or a relative, in a quiet English town or a crowded American city. It happens everywhere for all kinds…
v 4 obchodech

Strange and wonderful things happen in t seven short stories. Oscar Wilde takes us into a world of kings and queens,…
v 6 obchodech

Produkt Power Maths 2nd Edition Practice Book 6B zakoupíte na Bookshop.cz od nakladatele Pearson Education Limited.…
v 5 obchodech

Produkt Power Maths 2nd Edition Practice Book 4A zakoupíte na Bookshop.cz od nakladatele Pearson Education Limited.…
v 5 obchodech

Produkt Power Maths 2nd Edition Practice Book 3A zakoupíte na Bookshop.cz od nakladatele Pearson Education Limited.…
v 5 obchodech

Produkt Power Maths 2nd Edition Practice Book 5A zakoupíte na Bookshop.cz od nakladatele Pearson Education Limited.…
v 5 obchodech

Bug Club Comprehension is a fresh new approach that helps every child master comprehension. It uses a powerful and proven…
v 2 obchodech
![Cizojazyčná kniha Bug Club Comprehension Y5 Term 3 Pupil Workbook 16-pack - Casey, Catherine [EN] (2017, Taschenbuch, Pearson Education Limited)](https://d25-a.sdn.cz/d_25/c_img_gU_Cl/G3dB9IO.jpeg?fl=res%2C350%2C350%2C1%2Cfff%7Cwebp%2C80)
Bug Club Comprehension is a fresh new approach that helps every child master comprehension. It uses a powerful and proven…
v 5 obchodech

MEGAKNIHY.cz

Highly motivating differentiated Student Books develop confidence, fluency and problem-solving, supporting progression: *…
v 3 obchodech

In their new book From Mathematics to Generic Programming, C++ STL creator Alexander Stepanov and Information Retrieval…
v 3 obchodech

Imagine, at a terrifyingly aggressive rate, everything you regularly use is being equipped with computer technology. Think…
v 4 obchodech

In this updated and expanded edition of his bestselling guide to logo design, Irish graphic designer David Airey includes an…
v 3 obchodech

Combined with enhanced online eBook access, Pearson Baccalureate Theory of Knowledge (ToK)' 2nd Edition is a complete…
v 4 obchodech

Produkt Pearson Edexcel International A Level Mathematics Mechanics 2 Student Book zakoupíte na Bookshop.cz od nakladatele…
v 4 obchodech

Produkt Pearson Edexcel International A Level Mathematics Further Pure Mathematics 1 Student Book zakoupíte na Bookshop.cz…
v 4 obchodech

Produkt Pearson Global Politics for the IB Diploma Programme bundle zakoupíte na Bookshop.cz od nakladatele Pearson…
v 2 obchodech

Produkt Criminal Law zakoupíte na Bookshop.cz od nakladatele Pearson Education Limited.…
v 2 obchodech

Endorsed by Edexcel, this Student Book and ActiveBook bundle covers both the AS and A level courses for the Edexcel…
v 3 obchodech

Master core principles of business operations and processes with this must-read text. Operations and Process Management, 7th…
v 2 obchodech

Develop an in-depth understanding of the shifting complexities of global business environment International Business, 9th…
v 2 obchodech

Produkt Excellence in Business Communication, Global Edition zakoupíte na Bookshop.cz od nakladatele Pearson Education…
v 2 obchodech
Produkt Brock Biology of Microorganisms Biology, Global Edition + Mastering Biology with Pearson eText (Package) zakoupíte…
v 2 obchodech

One of Hollywood’s most successful actors, Tom Cruise has starred in numerous films since his début in Risky Business. Read…
v 2 obchodech

George and Lennie are friends and they have plans for the future. But Lennie is not very smart and he sometimes makes…
v 2 obchodech

Classic / British English This great story is set against the background of the French Revolution. Two men – one French, one…
v 2 obchodech

When Eddie dies, trying to save a child from a terrible accident, he wakes up in heaven. Heaven, he discovers, is a place…
v 2 obchodech

After the death of his beautiful wife Rebecca, Maxim de Winter goes to Monte Carlo to forget the past. There he meets and…
v 3 obchodech

Known world-wide as the painter of the Mona Lisa, for designs of flying machines and for his studies of the human body. He…
v 3 obchodech

Where learning is an unforgettable adventure! Welcome to Our Discovery Island, a six-level primary series that engages…
v 3 obchodech